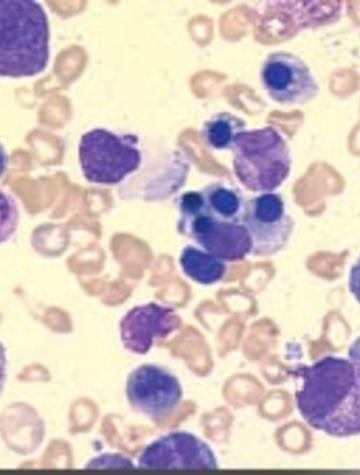

Carences en vitamine B12 et folates
Les déficits vitaminiques en B12 et B9 (folates) ont en commun des conséquences cliniques superposables, principalement aux plans hématologique et neurologique. Concernant le déficit en vitamine B12, la non-dissociation de la vitamine B12 de ses protéines porteuses est la cause la plus fréquente dans la population âgée. Carence en vitamine B12. Expression clinique. Fréquente, sa prévalence est estimée entre 15 à 40 %. Ses principales conséquences sont hématologique (anémie) [...]





